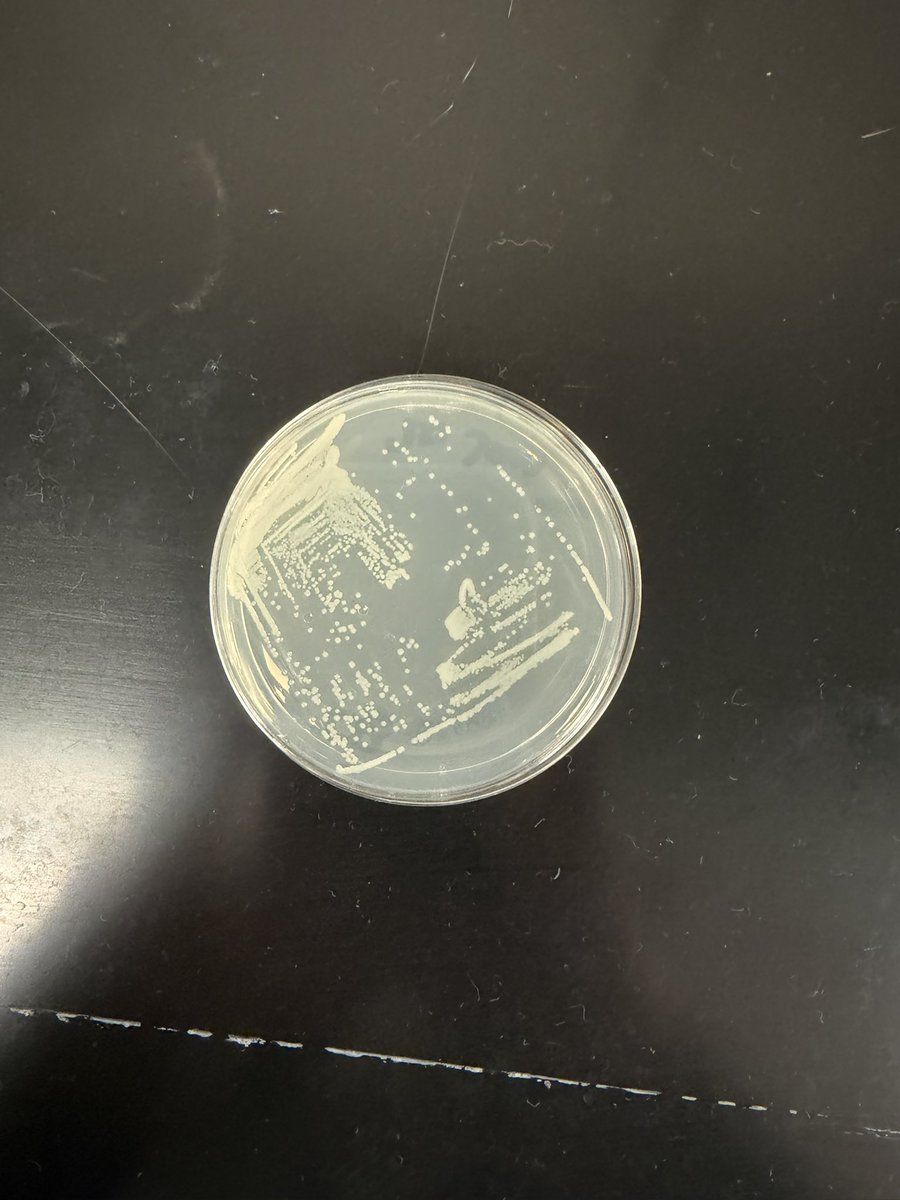
Kelsey Wilson tweet media

Irving ISD CTE retweetledi

Singley Academy culinary students hosted Polished Plate, an upscale lunch they designed and executed from start to finish. 🧑🍳🍴 This new initiative showcases their skills through a curated three-course dining experience while connecting with community supporters. Thank you to district partner, @PogueConstruct for attending and supporting our students! ✨




English